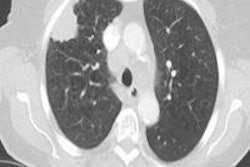

Dr. Sam Hare, consultant thoracic radiologist, and colleagues, from Barnet Hospital National Health Service Royal Free London Foundation Trust in Hertfordshire, U.K. have won the first NHS Innovation Challenge Prize for cancer, according to the trust.
The 100,000 pounds (130,000 euros) in prize money will be used to further development of a method for performing ambulatory lung biopsies. The new technique allows patients to leave the hospital just a half hour after the test is performed rather than the previous four-hour minimum stay, the trust wrote on its website.
The use of new techniques and portable equipment have enabled the trust to increase the number of biopsies it performs each year tenfold, reducing patient admissions and cutting costs by about 90%, the hospital said. Introduction of the new technique is especially timely considering the increasing use of lung cancer screening with CT, the trust said.
Wider use of the technique could free up hundreds of hospital beds while allowing more patients to undergo diagnostic biopsy more quickly, leading to earlier lung cancer diagnosis.